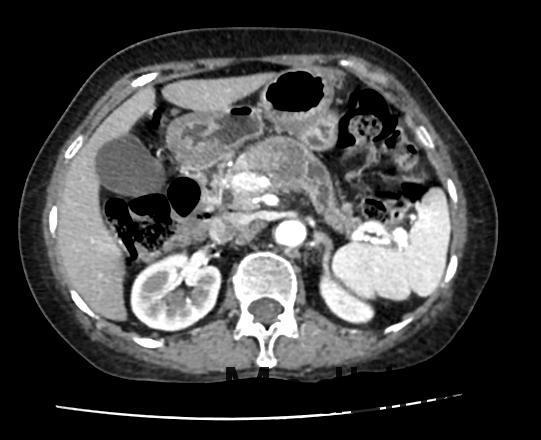

下载或打开 医联APP 查看完整评论
立即下载
打开APP
患者女,72岁,主因“消瘦半年,查体发现胰腺肿物1月”入院;患者半年前开始无明显诱因出现消瘦,体重逐渐减轻,约有3Kg。肿瘤标志物检查:癌胚抗原和CA-199增高。腹部CT平扫和腹部CT增强检查示:胰腺颈部肿瘤性病变,考虑胰腺癌可能性大。现为进一步诊治收入我科。
查体:无异常。 辅助检查:肿瘤标志物;癌胚抗原7.82ng/ml↑,CA-199197,60U/ml↑。 腹盆CT平扫;1、胰腺颈部不规则低密度影,占位性病变待除外,建议增强CT检查。 腹部CT增强;1、胰腺颈部肿瘤性病变,考虑胰腺癌可能性大,建议进一步检查。
诊断:1.胰腺肿物 胰腺癌 治疗:腹腔镜探查、转开腹胰体尾+脾切除术(术中冰冻病理提示胰腺癌)

术后二十天,患者顺利出院,未发生胰瘘等并发症,术后半年复查未见复发。